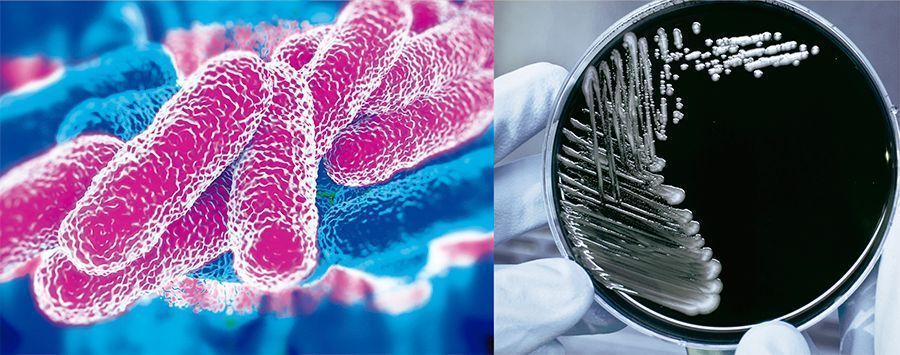
artnormlegionela 1

El Grupo de Fabricantes de Equipos de Enfriamiento Evaporativo de AEFYT, Asociación Española del Frío y sus Tecnologías, ha colaborado en la revisión de la Norma UNE 100030.
Los elementos más destacados de la nueva norma son:
> Definición del Plan de Prevención y control de la diseminación de la bacteria en las instalaciones.
> Tomas de muestras y análisis de la Legionella: toma y transporte de muestras, ensayos microbiológicos y fisioquímicos, métodos alternativos al cultivo para la diseminación de la legionella, generación de informes.
> Inclusión de nuevas instalaciones de riesgo, de modo que, en la actualidad, la norma contempla: agua fría de consumo (AFC), agua caliente sanitaria (ACS), torres de refrigeración y condensadores evaporativos, humidificadores, centrales humidificadores y enfriadores evaporativos, agua climatizada con agitación constante (SPA´S y bañeras hidromasaje), fuentes ornamentales y riego urbano por aspersión, nebulizadores y otras (por ejemplo, lavado de vehículos).
> Nuevos protocolos de actuación y desinfección.
> Requisitos del personal titular de la instalación: adecuada formación en mantenimiento, solvencia técnica, etcétera.
Desde AEFYT se valora positivamente la actualización de la norma, en especial la incorporación de nuevas instalaciones y los protocolos de actuación establecidos. César Fernández Achucarro, miembro del Grupo de Fabricantes de Enfriamiento Evaporativo de AEFYT, incide en cómo “la nueva normativa aporta mayor seguridad a los ciudadanos ya que, por primera vez, se incluyen como instalaciones susceptibles al control los humidificadores usados en terrazas y bares. Las torres siempre han estado en el punto de mira de los inspectores de Sanidad, pero gracias al compromiso de los profesionales del sector hemos incrementado la seguridad. Prueba de ello es la escasez de brotes en los últimos años en este tipo de instalaciones”.
En la misma línea, se pronuncia Javier Vaquero, también miembro del Grupo de Fabricantes de Enfriamiento Evaporativo de AEFYT, “la nueva Norma UNE 100030 constituye un marco técnico para la prevención y control de la Legionella, incorpora una extensa lista de instalaciones en las que ésta es capaz de proliferar y dispersarse, evitando la antigua clasificación de alto o bajo riesgo, que era una simplificación carente de rigor científico. Además se incorporan instalaciones que, según la experiencia de los últimos años, han sido causantes de algunos de los brotes más dañinos en España. Por otra parte, contempla todos los aspectos relacionados con la prevención y control: diseño, explotación, responsabilidades, formación, solvencia técnica, prevención, control, revisión, desinfecciones, etc.”
La participación de AEFYT en la redacción de la nueva norma ha sido crucial, con la introducción en el texto definitivo de muchas de sus indicaciones. En este sentido, cabe destacar cómo se ha trabajado intensamente en promover la detección precisa y fiable de los niveles de Legionella en las muestras, lo que, en opinión de Javier Vaquero, “va a permitir discernir de forma rápida la necesidad de proceder a realizar la limpieza y desinfección de las instalaciones cuando sean potencialmente peligrosas, o por el contrario, evitar gran cantidad de intervenciones protocolarias e innecesarias cuando no lo sean. De esta manera se conseguirá alargar la vida de los equipos y se evitará el vertido de ingentes cantidades de productos químicos contaminantes”.

El 11 de mayo, se celebrará la Jornada Técnica “Actualización Norma UNE 100030. Nuevo marco de Prevención y Control de la Legionella”, organizada por ANECPLA, Aqua España y F.E.D.E.C.A.I., que contará con la participación de AEFYT. En el encuentro se analizarán todos los aspectos realizados con la normativa de mano de los principales agentes del sector.



La revisión de la Norma UNE 100030, que establece el marco de prevención y control de la Legionella, con objeto de introducir los aspectos necesarios para proceder a su actualización y ajustarla a las necesidades del mercado.